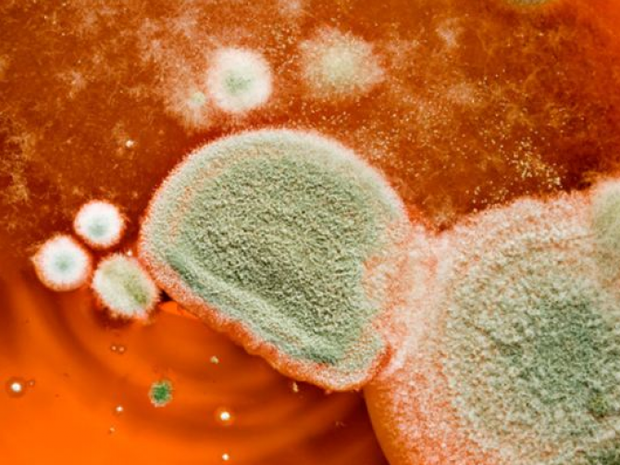

Трохи плісняви на хлібі, помідорі чи лимоні – знайомо усім. Її зазвичай, обрізають, а решту неушкодженого продукту споживають. Та чи можна це робити?
Як передає Zhyvyaktyvno, навіть якщо окраєць батона вкрився пліснявою – необхідно викинути у смітник все, адже більшість плісняви не помітна.
Ми не радимо видаляти запліснявілі шматки і вживати хліб у їжу, адже клітини грибків легко проникають у весь продукт і є у ньому, навіть якщо ви їх не бачите,
– наголосила фахівець United States Department of Agriculture Маріанна Грейвлі.
Якщо хліб був попередньо порізаний, це може перешкодити поширенню цвілі по всій буханці, але не гарантує безпеки.

Також медики наголошують, що не можна нюхати цвіль. В людини, яка вжила продукт з цвіллю, можуть розвинутися алергія та розлади дихання.
Навіть вдихання спор пліснявого грибка може бути небезпечним. Чим їжа м'якша, тим легше цвілі проникнути у весь шматок продукту. Саме тому хліб, м'які фрукти, м'ясо і джеми, які запліснявіли навіть з одного краю, слід викидати відразу.
А от тверді сири і тверді овочі можна сміливо очищати від цвілі і вживати в їжу. Також якщо одна з полуниць чи малин в контейнері запліснявіла, то немає потреби викидати всі ягоди. Просто переконайтеся, що цвіль не поширилась на інші ягоди.
Якщо у вас часто пліснявіють продукти – спробуйте частіше мити холодильник, це допоможе продуктам довше зберігатися.
Звісно, існують їстівні типи цвілі, зокрема, популярні особливі види твердих сирів з цвіллю.

Більше новин, що стосуються лікування різноманітних захворювань, медицини в Україні, здорового способу життя та харчування, вагітності та пологів, відкриттів у сфері медицини та багато іншого – читайте у розділі Здоров'я.
24.ua
Трохи плісняви на хлібі, помідорі чи лимоні – знайомо усім. Її зазвичай, обрізають, а решту неушкодженого продукту споживають. Та чи можна це робити?
Як передає Zhyvyaktyvno, навіть якщо окраєць батона вкрився пліснявою – необхідно викинути у смітник все, адже більшість плісняви не помітна.
Ми не радимо видаляти запліснявілі шматки і вживати хліб у їжу, адже клітини грибків легко проникають у весь продукт і є у ньому, навіть якщо ви їх не бачите,– наголосила фахівець United States Department of Agriculture Маріанна Грейвлі.
Якщо хліб був попередньо порізаний, це може перешкодити поширенню цвілі по всій буханці, але не гарантує безпеки.
Також медики наголошують, що не можна нюхати цвіль. В людини, яка вжила продукт з цвіллю, можуть розвинутися алергія та розлади дихання.
Навіть вдихання спор пліснявого грибка може бути небезпечним. Чим їжа м'якша, тим легше цвілі проникнути у весь шматок продукту. Саме тому хліб, м'які фрукти, м'ясо і джеми, які запліснявіли навіть з одного краю, слід викидати відразу.
А от тверді сири і тверді овочі можна сміливо очищати від цвілі і вживати в їжу. Також якщо одна з полуниць чи малин в контейнері запліснявіла, то немає потреби викидати всі ягоди. Просто переконайтеся, що цвіль не поширилась на інші ягоди.
Якщо у вас часто пліснявіють продукти – спробуйте частіше мити холодильник, це допоможе продуктам довше зберігатися.
Звісно, існують їстівні типи цвілі, зокрема, популярні особливі види твердих сирів з цвіллю.

Більше новин, що стосуються лікування різноманітних захворювань, медицини в Україні, здорового способу життя та харчування, вагітності та пологів, відкриттів у сфері медицини та багато іншого – читайте у розділі Здоров'я.
24.ua
Українцям перерахували пенсії по інвалідності 3 групи: хто з 1 травня отримає більше
Як виростити ідеальні огірки: Поради та секрети